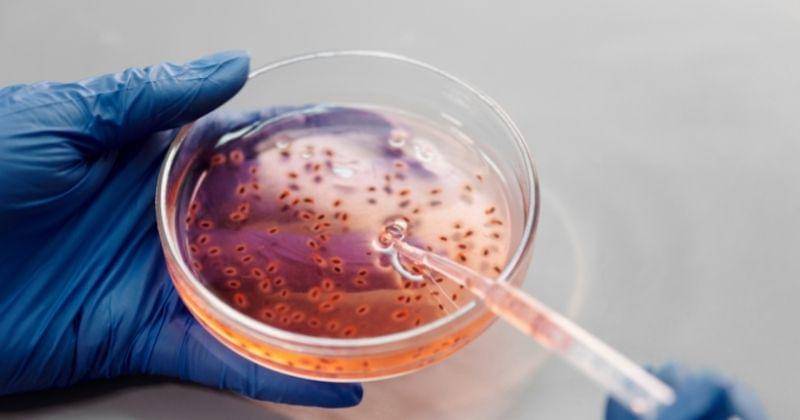
Pexels/Edward-jenner

Benarkah Cacar Monyet Bisa Menular Melalui Hubungan Seks?

Gejala kasus cacar monyet sama seperti kasus cacar biasa, tetapi para peneliti menduga cacar monyet bisa menyebar melalui hubungan seksual.
Asumsi ini berdasarkan angka kasus infeksi yang semakin tinggi di antara laki-laki yang berhubungan seksual.
Berikut Popmama.com merangkum ulasan seputar dugaan cacar monyet bisa menular melalui hubungan seks.
1. Asumsi penyebaran cacar monyet melalui hubungan seks

Dokter Penelitian Cacar WHO, Rosamund Lewis mengatakan bahwa ada kemungkinan kasus cacar monyet menyebar melalui hubungan seks di antara laki-laki. Asumsi ini berdasarkan angka kasus infeksi yang semakin tinggi di antara laki-laki.
"Kami telah melihat beberapa kasus di Eropa selama lima tahun terakhir, hanya pada pelancong, tetapi ini adalah pertama kalinya kami melihat kasus di banyak negara pada saat yang sama, terutama pada orang yang belum bepergian ke daerah endemik di Afrika," kata Rosamund.
2. Cacar monyet bukan infeksi menular seksual

WHO mengonfirmasi bahwa cacar monyet memang bisa menyebar melalui hubungan seksual. Namun, cacar monyet tidak tergolong infeksi menular seksual yang bisa menyebar melalui air mani atau cairan vagina.
WHO menyebut cacar monyet bisa menginfeksi siapa saja. Namun, berdasarkan data terkini, lonjakan kasus cacar monyet berasal dari hubungan seks di antara komunitas gay, biseksual dan laki-laki yang berhubungan seks dengan laki-laki.
"Banyak penyakit dapat menyebar melalui kontak seksual. Anda bisa terkena batuk atau pilek melalui kontak seksual, tetapi itu tidak berarti bahwa itu adalah penyakit menular seksual," kata Penasihat WHO tentang HIV, Hepatitis, dan Penyakit Lainnya, Andy Seale.
3. Cara penularan cacar monyet
Cacar monyet menyebar melalui kontak erat antara manusia, hewan, atau benda yang terkontaminasi virus. Virus kemudian memasuki tubuh melalui jaringan kulit yang rusak, saluran pernapasan, mata, hidung, atau mulut.
Virus yang menyebar antar manusia biasanya akan masuk melalui kulit yang rusak, saluran pernapasan, hidung, atau mulut. Para peneliti juga menemukan virus bisa menular melalui tetesan pernapasan. Namun, hal ini masih membutuhkan penelitian lebih lanjut.
DEmikian ulasan mengenai cacar monyet bisa menular melalui hubungan seks. Oleh karena itu, penting untuk menjaga kebersihan diri sendiri dan lingkungan sekitar agar terhindar dari penularan cacar monyet maupun virus lainnya.















-8gfDIgtKoZ2WGLEKFGDlPwT4RpyIqlI3.jpg)


-QhxF8Ou7dnGCYsPQ2z0PvH7c9nW4s37P.jpg)
